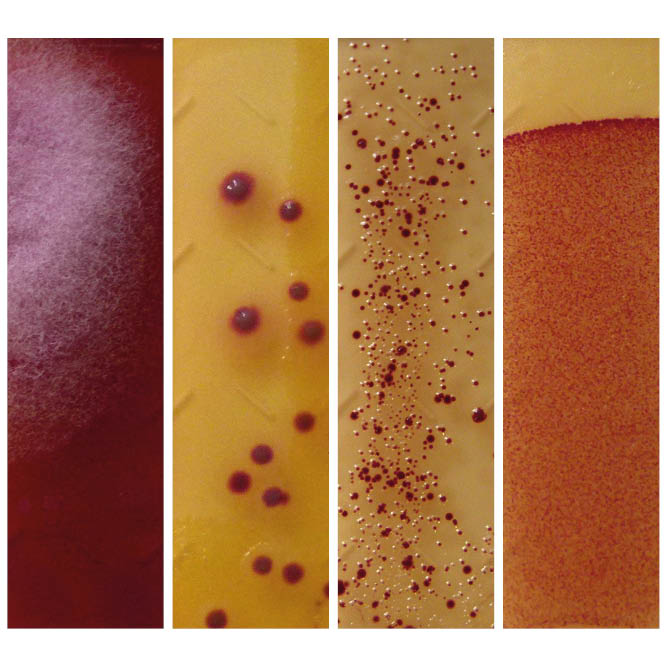

İçin Chem-Trend® SL-6XXXX Ayırıcı Maddeler

Chem-Trend® SL-6XXXX ayırıcı madde serisi, ileri üretim süreçlerini olumsuz etkilemeden çeşitli uygulamalarda gözle görülür iyileştirmeler sağlayan kapsamlı bir ürün yelpazesi sunar.
Chem-Trend® SL-6XXXX Serisinin Avantajları
- Geniş sıcaklık aralığında ve yüksek kalıp sıcaklıklarında daha iyi ayırıcı film tutunması
- Optimum ayırıcı film oluşum süresinin kısalması
- Kalıpta metal yapışmalarına karşı gelişmiş koruma
- Karmaşık geometrilere sahip döküm parçaların kolayca kalıptan çıkarılması
- Daha düşük gözeneklilik (daha az gaz sıkışması)
- Kalıpların, ekipmanların ve makinelerin korozyona karşı daha yüksek koruma
- Çok düşük boyutsal toleranslara sahip döküm parçalar için uygunluk
Bio Inhibiting Technology BIT™ – Mikrobiyolojik Sorunlara Karşı Formül
Mikrobiyolojik kontaminasyon, ayırıcı maddelerin etkinliğini azaltabilir ve püskürtme başlıklarında, hatlarda ve parça yüzeylerinde kirlenmeye neden olabilir.
Chem-Trend, mikroorganizmaların olumsuz etkilerini büyük ölçüde azaltan ve kirlenme ile balçık oluşumunu etkili şekilde önleyen güçlü bir teknoloji geliştirdi. BIT™ teknolojisine sahip ayırıcı maddeler sayesinde dökümhaneler mikrobiyolojik sorunları kontrol altına alabilir ve üretim süreçlerini sorunsuz şekilde sürdürebilir.
Daha fazla bilgi için broşürümüzü inceleyin.